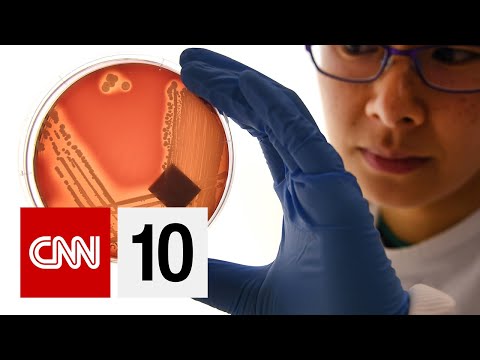
超級細菌的問題|2019年11月15日。 (The Problem With Superbugs | November 15, 2019)

10,000 個「 超級簽渠道常見穩定性問題-TG:@iossteven1✔️fuliios超級簽代理.obu 」的搜尋結果
依關聯性
03:09
53:14
01:36
03:31
07:02
14:15
04:39
07:08
43:36
03:43
06:51字幕已審核
03:05
03:05
12:23
02:01
04:44字幕已審核
04:03
04:03
03:46字幕已審核
01:53
01:53字幕已審核
07:28
07:28字幕已審核
05:08
05:08
14:04
06:22
03:22
11:01
05:53